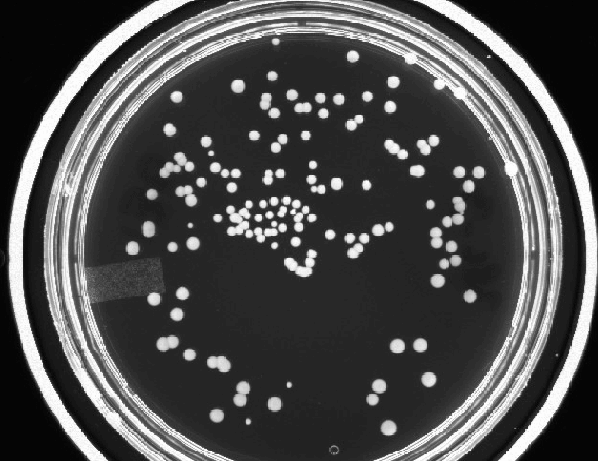

Click on the gif animation to see how Scorpion counts overlapping and different sized circles.

Tordivel, Scorpion 3D Stinger and Scorpion Vision Software Blog
Click on the gif animation to see how Scorpion counts overlapping and different sized circles.